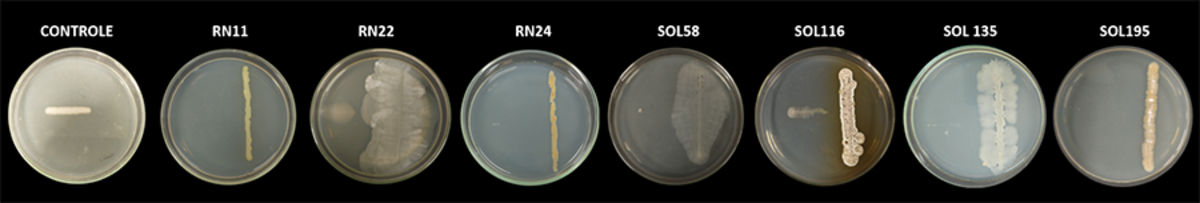

Bactérias encontradas em rios amazônicos controlam agente causador da murcha bacteriana do tomate
Quanto à ocorrência da doença, em ensaios durante as estações seca e chuvosa, reduziu a incidência da murcha bacteriana em 40% e 90%, respectivamente, ao mesmo tempo em que promoveu o crescimento das plantas infectadas

- A murcha bacteriana é uma das maiores ameaças à produção de tomate na Amazônia e afeta também outras culturas. Cientistas avaliaram o potencial de microrganismos isolados dos sedimentos dos rios Solimões e Negro para controlar a Ralstonia solanacearum, bactéria causadora da doença. Do total de 36 selecionados, foram identificadas três bactérias que demostraram maior capacidade de inibir o crescimento do fitopatógeno nas plantas. Os resultados do estudo são promissores para o desenvolvimento de soluções biológicas eficazes para conter a incidência da doença. E representam um avanço científico na pesquisa com microrganismos, evidenciando o potencial biotecnológico da diversidade microbiana amazônica. O estudo foi conduzido por pesquisadores da Embrapa, Universidade Federal do Amazonas, Universidade do Estado do Amazonas e do Instituto Nacional de Pesquisas da Amazônia.

Resultados da pesquisa evidenciam o potencial biotecnológico da diversidade microbiana amazônica. Na foto, rio Negro
Estudo conduzido por cientistas brasileiros mostrou que microrganismos oriundos de rios amazônicos podem ser a chave para o controle biológico da bactéria do solo Ralstonia solanacearum, responsável pela murcha bacteriana em tomateiros. Os resultados são promissores para o desenvolvimento de soluções biológicas - a exemplo de inoculantes microbianos - eficazes para reduzir a ocorrência da doença, uma das maiores ameaças à produção de tomate na Amazônia e capaz de afetar também outras espécies vegetais.
O estudo, coordenado pelo pesquisador da Embrapa Amazônia Ocidental Gilvan Ferreira da Silva, avaliou o potencial de bactérias isoladas dos sedimentos dos rios Solimões e Negro para combater a murcha bacteriana. Do total de 36 bactérias selecionadas, foram identificados três isolados bacterianos, o Priestia aryabhattai RN 11, o Streptomyces sp. RN 24 e o Kitasatospora sp. SOL 195, que demostraram uma notável capacidade de inibir o crescimento da Ralstonia solanacearum em 100%, 87,62% e 100%, respectivamente.
Quanto à ocorrência da doença, em ensaios durante as estações seca e chuvosa, P. aryabhattai RN 11 reduziu a incidência da murcha bacteriana em 40% e 90%, respectivamente, ao mesmo tempo em que promoveu o crescimento das plantas infectadas. Streptomyces sp. RN 24 e Kitasatospora sp. SOL 195 exibiram altas taxas de sobrevivência (85 a 90%) e supressão do patógeno no solo (maior que 90%), demonstrando seu potencial como agentes de biocontrole. Fotos abaixo: Jennifer Salgado.

O isolado P. aryabhattai RN 11, em particular, destacou-se por sua eficácia na supressão do fitopatógeno no solo, reduzindo a incidência de murcha bacteriana e promovendo o crescimento das plantas de tomate sob diversas condições climáticas. Além de sua ação de controle da doença no tomateiro, essas bactérias também demonstraram a habilidade de produzir enzimas extracelulares e compostos que promovem o crescimento das plantas
A descoberta de possíveis novas espécies de Streptomyces (RN 24) e Kitasatospora (SOL 195) reforça a importância da biodiversidade microbiana da Amazônia como fonte de compostos bioativos e agentes de biocontrole. Esses achados evidenciam, ainda, a necessidade de estudos futuros para explorar o potencial dessas novas espécies, avaliar a eficácia dos isolados em condições de campo e entender os mecanismos moleculares envolvidos na interação planta-microrganismo.
A pesquisa foi direcionada no sentido de contribuir para o manejo sustentável da murcha bacteriana em tomates, mas esse potencial de biocontrole da doença pode se estender a outras plantas. "A Ralstonia solanacearum é uma bactéria de solo que ataca dezenas de outras espécies vegetais como a batata, o pimentão, a pimenta, a berinjela, a banana, o amendoim, o feijão e a soja", lembra Ferreira.
Potencial amazônico - O estudo faz parte de pesquisas coordenadas pelo microbiologista Gilvan Ferreira da Silva, que tem estudado a microbiota da Amazônia com foco no desenvolvimento de soluções para a agricultura. Os trabalhos realizados por sua equipe de pesquisa têm como característica o aspecto multidisciplinar envolvendo diferentes abordagens, além da agrícola e microbiológica, incluindo a química de produtos naturais, a genômica e a bioinformática.
A identificação de microrganismos retirados de sedimentos de rios amazônicos vem sendo feita pela Embrapa Amazônia Ocidental a partir de coletas nos rios Madeira, Purus, Solimões, Juruá e Negro, realizadas entre 2018 e 2019. Na ocasião, as coletas de sedimentos foram feitas a cada 50 km, no percurso desses rios.


Foto: Siglia Souza (rio Negro) e Jennifer Salgado (planta doente)
Após análises no Laboratório de Biologia Molecular do centro de pesquisa, foi identificada uma grande diversidade de microrganismos com potencial para o desenvolvimento biotecnológico voltado à produção de bioinsumos, ao controle de patógenos de interesse agrícola, à promoção do crescimento de plantas, a aplicações em atividades industriais, entre outras aplicações.
Os resultados dessa pesquisa também representam um avanço científico na pesquisa com microrganismos, destacando o potencial biotecnológico da diversidade microbiana amazônica.
Ferreira destaca que o resultado obtido com o biocontrole de Ralstonia solanacearum é um dos primeiros trabalhos reportando a aplicação agrícola dos microrganismos oriundos dos rios amazônicos. "Há outros em andamento, mostrando que microbiota do Bioma Amazônia, principalmente a dos rios, pode ter uma aplicação importante na agricultura, tanto na parte de controle de patógenos quanto na prospecção de novas moléculas. Então é um material muito rico que está sendo desdobrado em diversos trabalhos".
O pesquisador costuma usar o termo "mineração genômica", se referindo aos microrganismos como "minérios" ou "tesouros". E afirma que sua prospecção pode ser mais rentável economicamente do que a de minérios tradicionais. Diante da diversidade existente na região amazônica, o pesquisador explica que é necessário selecionar, por meio de técnicas científicas, os microrganismos de acordo com a aplicação almejada, fazer o sequenciamento de genomas completos, para então fazer a mineração genômica daqueles de interesse, visando à prospecção de moléculas de substâncias que tenham alto valor agregado biotecnológico.
Artigo publicado - O estudo consta no artigo "Amazonian Bacteria from River Sediments as a Biocontrol Solution against Ralstonia solanacearum" publicado no periódico Microorganisms, e reúne como autores os pesquisadores Jennifer Salgado da Fonseca e Thiago Fernandes Sousa, do Programa de Pós-Graduação em Biotecnologia da Universidade Federal do Amazonas (UFAM); Suene Vanessa Reis de Almeida e Carina Nascimento Silva, além do professor Rogério Eiji Hanada, do Programa de Pós-Graduação em Agricultura no Trópico Úmido do Instituto Nacional de Pesquisas da Amazônia (Inpa); Gleucinei dos Santos Castro e o professor Hector Henrique Ferreira Koolen, do Programa de Pós-Graduação em Biodiversidade e Biotecnologia da Universidade do Estado do Amazonas (UEA); Michel Eduardo Beleza Yamagishi, da Embrapa Agricultura Digital; e Gilvan Ferreira da Silva, da Embrapa Amazônia Ocidental, que coordenou a pesquisa. *Síglia Souza/Embrapa Amazônia Ocidental - [email protected] - Telefone: (92) 3303-7852.


 Acervo digital
Acervo digital Artigos Técnicos
Artigos Técnicos Anunciantes
Anunciantes Eventos
Eventos Notícias do Pomar
Notícias do Pomar Tecnologia
Tecnologia Vídeos
Vídeos


